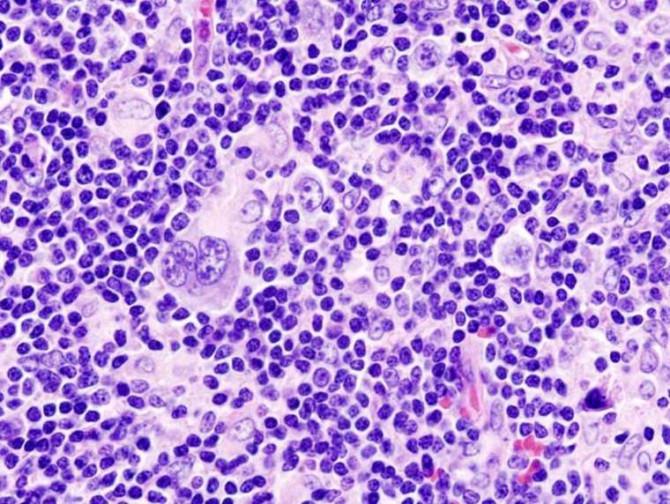

Лімфома – лікування лімфоми народними засобами і методами
Лікування лімфоми чистотілом
Чистотіл заготовляють наприкінці квітня, в період цвітіння. Стебло, листя, квіти і корені потрібно акуратно очистити від бруду, не мити і не м’яти. Нарізати ножем з нержавіючої сталі, засипати в 3 літрову банку, добре утрамбувати, придавлюючи качалкою, зав’язати марлею і поставити в темне місце.
Щодня за допомогою дерев’яної палички 3-5 разів на день протикати сировину. На 4 день вичавити макуха, виходить приблизно 600-700г соку. Відстояти сік 2 доби в темному місці. А макуха залити 500-700 г горілки або самогону і настояти в темному місці 8-9 днів, потім віджати і поставити настоюватися, як і сік.
Через три дні настій готовий. Зберігати в темному місці. Пляшки із соком і настоєм підписати, щоб надалі не переплутати. Настій використовують для зовнішнього застосування (порізи, попрілості, і також додають в мікроклізми при лікуванні поліпів прямої кишки). Соком чистотілу лікують онкологічні захворювання будь-якої локалізації.
Прийом засобу:
- при 1-2 ступеня по 1 ст. л. на 100 г молока або кисломолочних продуктів, 1 раз в день перед сном, запивати молоком. На курс потрібно трохи більше 0,5 л.
- при 3-4 стадії по 1 ст. л. на 100 г молока 2 рази на день з перервою 12 годин. Знадобиться трохи більше 0,7 л зілля.
В цілях профілактики потрібно випивати 350 р. Після курсу лікування обов’язково здаються аналізи, якщо поліпшення немає, повторюють курс.
Причини захворювання
Наука точно не знає про походження цієї хвороби. Тому вона тільки розкриває фактори ризику. Це відноситься до надмірного впливу ультрафіолету.
На прогноз впливає:
- підвищений рівень радіації;
- недостатній захист від пестицидів, тим, хто пов’язаний з сільським господарством;
- СНІД;
- трансплантація органів;
- лікування з допомогою иммуннодепресантов.

Якщо стадія буде визначена, то фахівці отримають інформацію про хвороби, про його поширеності в зонах організму. І ці отримані знання, насправді дуже значимі для прогнозу. Все це необхідно для того, щоб вибрати адекватні дії, які допоможуть скласти ефективні програми для лікування хвороби.
Захворювання класифікується за 4 стадій. Це загальноприйнята міжнародна класифікація. Номер стадії може закінчуватися літерами А і Б. Ці літери визначають важливі симптоми: лихоманку, виражену нічну пітливість, втрату ваги. Якщо стадія позначається буквою А, то таких симптомів немає. А якщо Б, то навпаки.
До місцевих, локальних, обмеженим відносяться перші дві стадії. Поширені захворювання спостерігаються у хворих на останніх стадіях, коли хвороба приймає агресивні форми розвитку.
Сама початкова форма тільки зароджується з хворобою, її ступінь дає можливість залучення до хвороба лімфатичних вузлів з однієї зони.
Інша ступінь хвороби після початкової пускає свої щупальця на кілька об’єктів в області з тієї сторони м’язового листка, де зона ділиться між грудною кліткою і черевної частиною (діафрагма).
На 3 стадії хвороба захоплює область лімфатичних вузлів вже з двох сторін перегородки, діафрагми.
На 4 стадії спостерігається ураження лімфатичних вузлів з переходом на область серця, печінки, нирок, кишечника і т. д.
Вироблений спеціальний план, за яким можна визначитися з діагнозом після бесіди з лікарем.
Пацієнта запрошують на лікарський огляд.
Лікарі направляють на здачу загальноклінічних біохімічних аналізів крові.
Проводиться біопсія. Хірургічно видаляється лімфатичний вузол або шматочки тканини ураженої зони. Її досліджує лікар патоморфолог, після чого дає висновок про наявність або відсутність ракових клітин. І якщо є лімфома, він визначає її вид.
| № | Корисна інформація |
|---|---|
| 1 | виявити пухлинні новоутворення на тих органах, і в тій зоні, які можна переглянути при зовнішньому обстеженні (припустимо, в маргінальній) |
| 2 | допомагає визначати лімфоми і давати прогноз |
Досліджується також кістковий мозок для встановлення пухлинних клітин.
При додаткових методах дослідження встановлюється особливість лімфоми. Це відбувається з допомогою иммуннофенотипирования (метод проточної цитометрії), цитогенетичними та молекулярно-генетичними дослідженнями.
Захиститися від хвороби практично неможливо, так як істинні причини і нині не встановлені. Але відомі фактори, які здатні збільшити ризик захворювання. До таких відносяться:
- систематичний контакт з хімічними засобами, наприклад, фарбами, гербіцидами або азбестом
- вірусні та бактеріальні інфекції, такі як, ВІЛ, Гепатит, Helicobacter Pylori
- куріння
- вживання великої кількості жирної їжі
Основною причиною появи лімфоми є збій лімфосістеми, яка починає виробляти патологічні лімфоцити замість здорових клітин крові. Первинна пухлина може утворитися в лімфатичних вузлах або органах, нерідко вражає кістковий мозок, селезінку і печінку хворого.
Серед найбільш поширених факторів, що впливають на розвиток небезпечного захворювання:
- спадкова схильність;
- різні види імунодефіциту;
- вірус Епштейн-Барра;
- часті простудні захворювання, що провокують запалення і ослаблення імунітету;
- тривала робота з хімічними речовинами (кислотами, фарбами, азбестом, пестицидами);
- хвороби крові;
- неправильне харчування.
Всі лімфоми в залежності від типу злоякісних клітин діляться на хворобу Ходжкіна та неходжкінські. Вони мають схожі симптоми, але відрізняються агресивністю перебігу, особливостями лікування і підбором препаратів для хіміотерапії.
Лікування лімфоми пивом з каштана
Рецепт пива: Приготуйте 20-30 каштанів, збираючи їх далеко від шосе, разрубите їх на 2 частини, складіть у трилітрову банку. Подрібніть трави. Засипте в марлевий мішечок 5 ст. л. трави чистотілу, 2 ст. л. ромашки, 2 ст. л. календули, 2 ст. л. деревію і 2 ст. л. мати-й-мачухи. Туди ж покладіть шматочок кременя, і помістіть в бутель.
Залийте молочною сироваткою, 1 ст. л. сметани, зав’яжіть 2 шарами марлі і поставте на світло, уникаючи сонячних променів. Залиште бродити 2-3 тижні, потім зливайте по 1-2 склянки, випиваючи порціями протягом дня. У банку доливайте талу воду з медом. Існує багато методик лікування.
Лікування лімфоми народними засобами

Існує досить велика кількість рецептів лікування недуги. Який з них краще всього допомагає позбавиться від хвороби напевно ніхто не відповість, так як у кожної людини організм унікальний і індивідуальний. Тому підбір ліків повинен бути індивідуальний. Часто використовувані народні засоби проти лімфоми наступні.
Настій чистотілу
Його готують, використовуючи наступні інгредієнти:
- листя, стебла і квіти чистотілу;
- скляна банка.
Візьміть чистотіл дрібно наріжте його ножем. Отримане сировину щільно укладіть в банку таким чином, щоб воно пустило сік. Зав’яжіть посудину марлею і поставте її в темне місце. Кожен день дерев’яною палицею до п’яти разів на день протыкайте суміш в банку. Через три дні добре відіжміть кашку. Отриманий сік поставте на кілька днів у темне місце. Залишилася, кашку залийте горілкою і настоюйте протягом двох тижнів.
Спиртовий настій народні цілителі рекомендують використовувати для лікування порізів і попрілостей. Також його іноді додають для проведення процедур мікроклізм. Настій з соку чистотілу приймають всередину. При початкових стадіях по одній столовій ложці розбавляючи в 100 грамах свіжого молока не більше одного разу на добу. При 4 стадії приймати ліки потрібно в таких же дозах двічі на добу.
Лікувальна пиво
Його готують з наступних інгредієнтів:
- 25 каштанів;
- по 5 грам чистотілу, ромашки, календули, тысячелетник, мати і мачухи;
- молочна сироватка;
- 10 грам сметани;
- кремень.
Візьміть каштани, які були зібрані далеко від дороги і розріжте їх навпіл. Складіть отриману сировину в скляну банку. Потім до них додайте подрібнені трави в марлевому мішечку. До травам додайте невеликий шматочок кременя. Сировина залийте сироваткою і додайте сметану. Верх посудини закрийте двох шарової марлею.
Березовий дьоготь
https://www.youtube.com/watch?v=txFky0GydPk
Для використання даного продукту в якості лікування необхідно для приготування спеціального засобу використовувати наступні інгредієнти:
- 100 г березового дьогтю,
- 10 грам нашатирю.
Візьміть дьоготь і промийте його кілька разів. Після чого перемішайте до однорідної консистенції. В отриману масу додайте нашатир в порошку. З сировини потрібно замішати невеликі кульки розміром приблизно, як зерно і пересипати їх борошном. Отримане ліки потрібно зберігати в картонній коробці.
Приймати зцілюючий засіб потрібно перші три дні по одній кульці, після чого потрібно збільшити дозування до двох кульок. Курс такого лікування становить один місяць. Після чого слід зробити невеличку перерву і повторити курс.
Селеновая настоянка
Даний рецепт рекомендований народною медициною при лімфомі Ходжкіна. Для того, щоб її приготувати, потрібно використовувати наступні інгредієнти:
- 150 грам селену,
- 150 грам дистильованої води.
В скляній посудині селен розбавити в дистильованій воді. Струсніть посудину з отриманим сировиною 55 разів. Після чого поставте посудину в темне місце на добу, щоб засіб настоялося. Протягом наступних двох діб потрібно струшувати засіб по 20 разів. Готове ліки потрібно приймати по 4 краплі, розбавляючи в достатній кількості води по одному разу в добу.
Курс лікування становить три місяці. При необхідності курс можна повторити після трьох тижневої перерви.
Пам’ятайте перед тим, як лікувати лімфому народними засобами потрібно обов’язково проконсультуватися з лікарем, щоб не завдати не виправити шкоду організму.

Здоров’я Вам!
В першу чергу треба переглянути своє харчування, оскільки із-за хвороби імунітет буде сильно ослаблений. Дотримуйтеся основних правил:
- Харчування має бути регулярним, не рідше 4 разів на день, навіть при повній відсутності апетиту
- Повністю вилучити з раціону шкідливі продукти, наприклад, випічку і фаст-фуд, алкоголь
- Їжте більше сиру, риби, овочів і фруктів
- Перед прийомом їжі пийте журавлинний напій, а після – чай з ромашки
Чистотіл
Зберігати його потрібно в період цвітіння, тобто в кінці квітня. Акуратно очистити рослину від бруду, причому водою робити цього не варто. Подрібнити ножем, покласти в ємність, зав’язати марлею і залишити в темному місці. Щодня дану заготівлю потрібно кілька разів протикати. Через 4 дні макуха віджати.
У підсумку ви повинні отримати близько 700 р. соку, яким дати відстоятися 2 дні. Той макуха, який залишився потрібно залити горілкою близько 700 р. і залишити в темному місці на 8-9 днів. Після чого суміш віджати і дати відстоятися. Самогон для цих цілей теж підійде. Настій буде готовий до вживання через 3 дні.
Сік чистотілу можна використовувати незалежно від локалізації:
- лімфома 1-2 стадії: 1 ст. л. соку додавати в 100 р. молочних продуктів і пити перед сном
- лімфома 3-4 стадії: той же склад пити двічі на день з інтервалом 12 годин
По закінченні повного курсу лікування потрібно пройти обстеження, і прийняти рішення про можливе повторі.
Настій чистотілу на горілці використовується для зовнішнього застосування.
Березовий дьоготь
Для приготування ліків знадобиться 100 р. дьогтю, який потрібно 9 разів промити. Причому воду слід брати нову. Перемішати дьоготь до отримання однорідної маси, додати 10 г сухого нашатирю. Підсмажити борошно на чистій сковорідці, а потім, використовуючи всі інгредієнти, замісити тісто. З отриманої маси зробити кульки не більше зерна кукурудзи, які можна зберігати в коробці, пересипаючи попередньо їх борошном.
Приймати отримані кульки потрібно наступним чином:
- перші три доби пити по 1 шт. 4 рази на добу за годину до їжі
- час, що залишився, по 2 шт. 4 рази в добу
Запивати ліки рекомендується 100 мл відвару з подорожника, репешко і календули (по 50 г). 3 ложки цієї суміші потрібно варити в 3 ст. води протягом 10 хв. на повільному вогні.
Прополіс
Лікувати лімфому можна настоянкою прополісу.
Вам знадобиться 40 г прополісу, по 0,5 л. спирту 95% і 75%, 600 мл. гарячої води. Прополіс порізати і покласти в пляшки з темного скла. Залити спиртом 95%, збовтати і закупорити. Після цього залишити настій на 30 діб у темному місці, періодично струшуючи. По закінченні місяця частина рідини злити, залишивши при цьому осад, який розбавити спиртом 75% і залишити настій на 20 діб.
Залишився осад залити водою і залишити на кілька годин. Цей настій є відмінним засобом для підвищення апетиту. Для цього потрібно пити 15 мл настою в день. Також можна змащувати місця збільшених лімфовузлів.
Пиво з каштана
Для приготування пива знадобиться каштан в кількості 20-30 шт. Брати сировину краще в місцях, віддалених від шосе. Каштани треба розрубати навпіл і скласти в банку. Після цього потрібно приготувати трав’яний збір: 5 ложок чистотілу, по 2 ложки ромашки, календули лікарської, деревію і мати-й-мачухи.
Загорнути цей збір у марлю, додавши кремній, і опустити в банку з каштанами. Дану суміш залити молочною сироваткою, сметаною (1 ст. л.) і зав’язати двома шарами марлі. Після чого банку поставити на світ, однак не під прямі сонячні промені. Залишити суміш бродити на 15-20 днів. Після закінчення цього терміну зливати рідину по 1-2 ст., які потрібно випити за день. Після зливання засоби, в банку потрібно додати талу воду з додаванням меду.
Полин
Даний засіб призначений для позбавлення від найпростіших з організму людини, що сприяє підвищенню імунітету і очищення всього організму. Для приготування народного ліки вам знадобиться скляна посуд, або ж фаянсовий. У неї потрібно насипати кілька ложок полину, яку попередньо потрібно подрібнити.
Гриб саркосома
Знайти цей гриб можна на мохах і ялинової підстилці. Засіб з цього гриба потрібно брати для ін’єкцій.
7-8 свіжозрізаних грибів ретельно промити, залити медичним спиртом не довше 5 секунд. Виклавши на стерильний піднос, гриби висушити. Через 30 хвилин, використовуючи стерильний чим, зняти шапку і шприцом витягнути слиз. Далі цю слиз потрібно випустити в стерильну ємність і зберігати в холодильнику щільно закритим. Перед використанням засіб потрібно нагріти.
Лікування проводиться за наступною схемою:
- перший тиждень: 1 см3 1 раз кожні 3 дня
- другий тиждень: 2 см2 раз у 3 дні
- третій тиждень: 3 см3 на одну ін’єкцію
- наступні тижні: 3 см3 раз в 7 днів
Курс лікування триває 3 місяці. Для ефективності лікування потрібно чітко дотримуватися дозування.
Офіційна медицина вважає основними способами лікування лімфоми поєднання хіміотерапії і променевої терапії. Більш прості народні методи носять допоміжний характер, полегшуючи стан хворого. Офіційно не існує розробленого і доведеного рецепти позбавлення від пухлини лімфатичної системи за допомогою трав’яного настою або соку рослини.
Але зафіксовано чимало фактів, коли з їх допомогою тяжкохворі пацієнти краще справлялися з небезпечним захворюванням:
- збільшувався час ремісії;
- диагностировалось зменшення пухлини;
- прискорювалося час загоєння і відновлення після операції;
- піднімалися основні показники клітин крові без додаткових препаратів.
При лімфомі людина стрімко втрачає вагу, а його імунітет перестає відбивати атаки патогенних бактерій і вірусів. Методи народної медицини не зможуть позбавити від раку на 2-4 стадії, але допоможуть зменшити швидкість розростання пухлини і поширення злоякісних клітин. Їх ефективність доведена в період відновлення після проходження хіміотерапії, при прискоренні загоєння тканин після операції з видалення лімфовузлів.
Лікування лімфоми за методом Н.Шевченка

Змішати по 30 мл горілки (самогонки) та нерафінованої соняшникової олії. Охолодити і збовтати до утворення емульсії. Пити 3 рази в день, через рівні проміжки часу, нічим не запивати і не заїдати. Курс 10 днів, 5 днів перерва. Допускається розсмоктувати шматочок лимона. Після прийому утриматися від вживання їжі протягом години.
В період курсового лікування не можна їсти молочні продукти, жирне м’ясо, гострі і солодкі страви, крім меду. Після лікування робити аналізи, проходити УЗ діагностику і інші обстеження. Лікування може тривати три роки.
Лікування лімфоми полином
В організмі людини найпростіші в процесі своєї життєдіяльності створюють певні умови, які сприяють зростанню ракових клітин. Метод допомагає позбутися від зрілих особин, личинок і яєць, тим самим очищає організм.
В скляний або фаянсовий посуд насипаєте кілька ложок подрібненого полину. З желатину готуєте густий розчин і капаєте в розсипану полин. За допомогою голки скатываете кульку величиною зручною для проковтування. Подсушиваете на папері змазаній рослинною олією. Підсушений кулька перекладіть на чистий папір і нехай остаточно висушується. Проковтувати потрібно кілька кульок вранці натщесерце, запиваючи водою.
Лікування лімфоми горіховою настоянкою
Горіхову настоянку готують із зеленої шкаралупи в період розтріскування горіхових плодів.
Шкаралупу слід подрібнити ножем з нержавіючої сталі, засипати в літрову банку і залити горілкою або самогоном.
Суміш наполягають в темному місці при кімнатній температурі 8-10 днів, під поліетиленовою кришкою. Струшувати 1-2 рази вдень. Потім процідити через кілька шарів тканини і перелити в пляшки по 0,5 літра, намагаючись наливати до країв не залишаючи місця для повітря. Закупорити сургучем або парафіном.
Коріння рослини 1 ст. л. залити 200 мл медичного спирту, настояти два тижні в темному місці. Процідити і пити, починаючи з однієї краплі, щодня додаючи по краплі. Дійти до 20 крапель і якщо не спостерігається хворобливих відчуттів в животі та запаморочення довести обсяг до 40 крапель в день.
Взяти 100 мг двоокису селен додати до 100 мл дистильованої води, струсити 60 раз і настояти 1 день. Після чого 10 крапель настою розвести дистильованою водою до 100 мл, настояти протягом двох днів 2, струшуючи по 20 разів на день.
Пити по 2-4 краплі 1 раз на день, розбавляючи у 50 мл води. Лікування повинно тривати 2-3 місяці, перерва 2-3 тижні і потім знову повторити. Для посилення дії засобу, рекомендується доповнити лікування вітамінами С і Е, випиваючи по 100 мг.
Настоянка з пізньоцвіту як другорядне зміцнювальний засіб допоможе прискорити одужання. Для її приготування 1 цибулину пізньоцвіту (15 г) подрібнити ножем з нержавіючої сталі, залити 200 мл 400 спирту і настояти 5-6 днів.
Після проціджування покласти в настоянку 10 г кореня скорцонеры. І ще настояти 3 дні, пропустити через фільтр. Прийняти в перший день дві краплі за 20 хвилин до їжі, розбавивши 100 мл води. Далі наступні дні додавати по краплі дійти до 6 крапель, причому 6 крапель приймати три дні. Потім збавляти по краплі в тій же послідовності. Зробити перерву на 1 тиждень і знову повторити курс. Достатньо 3 курсу.
Лікування лімфоми березовим дьогтем
Необхідно 100 г березового дьогтю відмити в 9 водах, потім перемішати до однорідної консистенції добавить10 р нашатирю, перетертого в порошок, підсмаженого на сухій сковороді борошна. З цієї суміші замісити тісто і сформувати круглі кульки завбільшки з кукурудзяне зерно. Пересипати їх борошном, зберігати в картонній коробці,
Схема прийому:1-й, 2-й, 3-й день – приймати по 1 кульці 4 рази в день за годину до їжі. У наступні дні приймати по дві кульки.
Запивати 100 мл трав’яного відвару.
Рецепт відвару: Щоб його приготувати, треба змішати подрібнені по 50 г трави парила аптечної, листя подорожника великого і квіток календули лікарської. 3 ст. л. сировини проварити в 600 мл води 10 хвилин на повільному вогні. Остудити і пити, додаючи мед за смаком і сік лимона.
Лікування лімфоми зборами трав
При лімфомі, що вразила будь внутрішніх органів корисно приймати лікарський засіб, приготований із збору трав.
Рецепт №1: 30 г кореня родіоли рожевої, 160 г кореня катрана татарського, 20 г кореня переступня білого, 2 г кореня аконіту джунгарського і 50 г трави самосилу білого подрібнити, добре перемішати і залити цю суміш 2.300 л спирту. Настояти 28 днів. Процідити, перелити в пляшку і пити вранці 1 раз на день. Почавши з 1 краплі, довести до 35 крапель, потім зменшувати кількість дійти до 1 краплі в день. Розводити в 100 мл води. Знадобиться 2-3 курсу лікування.
Рецепт №2: змішати по 1 частини трави ястребінки волосистої, кореня цикорію, кореня ферулы, 2 частини кореня кульбаби. Додати 0,5 частини трави самосилу білого і 2 частини квіток чорнобривців. Взяти 1 ст. л. сировини залити 250 мл окропу, настояти півгодини, процідити, вживати по 1/3 склянки 3 рази на день через 40 хвилин після прийому їжі. Лікування проводити протягом місяця.
Рецепт №3: подрібнити 50 г трави полину гіркого, 20 г кореня лепехи, 15 г квітів бругмансии (дурман), 20 г чорнокореня (скорцонера) лікарського, 40 г листя подорожника, 2 г кореня аконіту джунгарського, 40 г кореня родіоли рожевої і 25 г трави теукриума (дубровника) білого.
Залити 2. 300 л спирту, настояти 28 днів. Пити, розбавляючи в 75 мл 1 раз на день, починаючи з 1 краплі, дійти, щодня додаючи по краплі до 45 крапель, потім збавляючи по краплі дійти до прийому однієї краплі. Курс такої народної терапії — 3-4 місяці.
Ефективне лікування народними засобами при лімфомі можна проводити з допомогою цілющих зборів.
Трави при поєднанні підсилюють дію один одного. Найбільш рекомендовані:
- ромашка, мати-й-мачуха, чистотіл;
- бузина, герань лугова, оман;
- кровохлебка лікарська, дягель, таволга;
- листя чорної смородини, корінь петрушки, корінь кульбаби.
При запаленні лімфовузлів можна використовувати збір з шишок чорної вільхи, змішаної з календулою.
Лікування лімфоми болиголовом
Рецепт настоянки: свіжі подрібнені квітки болиголова завантажити у скляну банку, заповнивши її вщерть. Залити горілкою, закрити, настояти 18 днів у темному прохолодному місці. Приймати вранці натщесерце:
- 1-ий день – в 6.00, за годину до їжі 10 крапель, в 11.00, 16.00 та о 21.00, через 2 години після їжі;
- 2-ий день приймати за такою ж схемою, додавши на одну краплю більше (11). Так кожен день, протягом 30 днів, додаючи по краплі, доведіть кількість прийому до 40 крапель в день.

Якщо при вживанні такої кількості настойки відсутні болі в серці, печінці, нирках та підшлунковій залозі, немає запаморочення і нудоти, то продовжуйте приймати по 40 крапель 4 рази на день протягом 10 днів, після чого щодня знижуючи прийняту дозу на 1 краплю, дійдіть до десяти крапель на прийом.
Перерва 5 днів, якщо знадобиться, повторіть курс лікування. Обов’язково під час лікування лімфоми необхідно дотримуватися дієти. Рекомендується вживати відварена у воді або молоці рис, варену і печений гарбуз. Виключити з раціону міцний чай, кава, какао, гострі приправи, ріпу, бобові культури. Корисно пити відвар з 30 плодів шипшини, доводячи три рази до кипіння в 600 мл води, щоразу трохи охолоджуючи.
Лікування лімфоми грибом
Гриб під назвою саркосома куляста, зростаючий на мохової і ялинової підстилці в старих хвойних лісах відомий своїми лікувальними властивостями давно. Його сік нагадує густу слиз. Це один з найсильніших біостимуляторів зміцнюють імунітет.
Ін’єкції соком саркосомы дуже ефективні в боротьбі з онкозахворюваннями. Необхідно взяти 7-8 свіжих грибів, вимити і занурити на кілька секунд у ємність з медичним спиртом. Після цієї процедури гриби просушити на стерильній тарілці. Через півгодини у кожного гриба стерильним ножем знімають капелюшки і викачують з них шприцом слиз, випускають її , в стерильний флакон, щільно закупорюють. Зберігати в холодильнику.
Перед кожним вживанням нагрівати природним способом до кімнатної температури.
Схема уколов:
- 1 тиждень кожні 3 дні вводять за раз за 1 см3 засоби;
- 2 тиждень кожні три дні по 2 см3 соку;
- 3 тиждень кожні три дні по 3 см3 соку;
- 4 і наступні тижні роблять 1 раз в 7 днів по 1 уколу з 3 см3 соку. Курс – 3 місяці. Рекомендується найсуворіше дотримання перерв між введенням уколів і дозувань.
Бережіть своє здоров’я, пам’ятайте, що здоровий спосіб життя це вірний шлях до зцілення, і відмінна профілактика онкологічних захворювань.